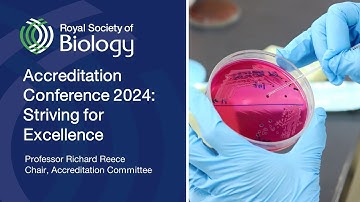
Accreditation overview | Accreditation Conference 2024 | Royal Society of Biology

⬇ DOWNLOAD NOW
Jika muncul iklan pop-up, tutup lalu klik tombol kembali
Download lagu Spring 2024 Background Briefing: Pathways towards Accreditation secara gratis hanya untuk keperluan promosi. Dukung artis favorit kamu dengan membeli musik original di iTunes atau platform resmi lainnya.
 Key Competencies and Best Practices Workshop - Background Briefing October 2024
Key Competencies and Best Practices Workshop - Background Briefing October 2024 Background Briefing: Education Interim Governance Boards
Background Briefing: Education Interim Governance Boards BACKGROUND BRIEFING first questions
BACKGROUND BRIEFING first questions Info Session for the Call ‘Piloting a Skills Guarantee for Workers in Transition’
Info Session for the Call ‘Piloting a Skills Guarantee for Workers in Transition’ Jan 2024: Committee Report outs
Jan 2024: Committee Report outs Accreditation overview | Accreditation Conference 2024 | Royal Society of Biology
Accreditation overview | Accreditation Conference 2024 | Royal Society of Biology Opening Plenary: Update on Leadership Transition and Survey of Developments, Trends, and Prospects
Opening Plenary: Update on Leadership Transition and Survey of Developments, Trends, and Prospects BSR Annual Conference 2024: Venue entrance
BSR Annual Conference 2024: Venue entrance